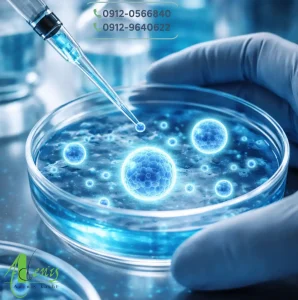
اگزوزوم تراپی چیست ؟

کاشت مو لیکن پلان
کاشت مو لیکن پلان؛ بررسی تخصصی امکانپذیری، ریسکها و تصمیمگیری اصولی موضوع کاشت مو لیکن پلان یکی از پیچیدهترین مباحث … ادامه مطلب
اگزوزوم تراپی چیست ؟
اگزوزوم تراپی چیست و چه نقشی در مسیر درمانهای نوین مو دارد؟ اگزوزوم تراپی چیست ؟ با پیشرفت روشهای تقویتی … ادامه مطلب

خونریزی بعد از کاشت مو
خونریزی بعد از کاشت مو؛ بررسی علتها، میزان طبیعی، زمان توقف و نکات کنترلی موضوع خونریزی بعد از کاشت مو … ادامه مطلب

قرص سیلدنافیل و کاشت مو
قرص سیلدنافیل و کاشت مو؛ بررسی علمی، تداخلها و نکات مهم موضوع قرص سیلدنافیل و کاشت مو یکی از پرسشهایی … ادامه مطلب

بوتاکس بعد از کاشت مو
بوتاکس بعد از کاشت مو؛ زمان مناسب، کاربردها و نکات مهم موضوع بوتاکس بعد از کاشت مو یکی از پرسشهایی … ادامه مطلب

نقاهت کاشت مو
نقاهت کاشت مو؛ مراحل بهبودی، مراقبتها و نکات مهم بعد از کاشت نقاهت کاشت مو یکی از مهمترین مراحل پس … ادامه مطلب

کاشت مو مردان
کاشت مو مردان؛ بررسی تخصصی شرایط، مراحل و انتظارات منطقی کاشت مو مردان یکی از پرتقاضاترین روشهای بازگردانی ظاهر مو … ادامه مطلب

کاشت مو روی اسکار یا زخم
کاشت مو روی اسکار یا زخم؛ بررسی علمی شرایط، محدودیتها و نتیجه کاشت مو روی اسکار یا زخم یکی از … ادامه مطلب

شرح کامل کاشت مو
شرح کامل کاشت مو؛ بررسی جامع مراحل، روشها و نکات مهم کاشت مو یکی از روشهای مؤثر برای بازگرداندن مو … ادامه مطلب

کاشت مو با خواب طبیعی
کاشت مو با خواب طبیعی؛ مهمترین معیار طبیعی دیده شدن نتیجه کاشت مو کاشت مو با خواب طبیعی یکی از … ادامه مطلب

دریافت وام کاشت مو
دریافت وام کاشت مو؛ شرایط، مدارک، مراحل و نکات مهم قبل از اقدام برای بسیاری از متقاضیان، هزینههای مرتبط با … ادامه مطلب

بی حالی بعد از کاشت مو
بی حالی بعد از کاشت مو ؛ علتها، مدت طبیعی و راههای بازیابی انرژی بی حالی بعد از کاشت مو … ادامه مطلب
